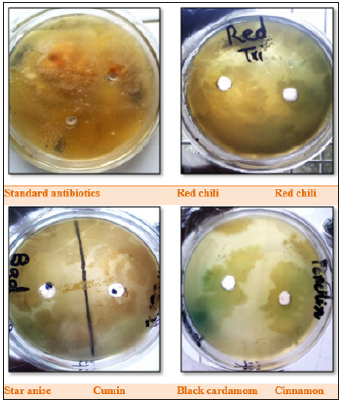
Click here to view Large image 8

Sahar S1*, Ullah F2, Hassan ULA3, Irfan JA4 and Laghari KA5
1Institute of Biotechnology and Genetic Engineering, Pakistan
2Department of Bioinformatics and Biotechnology, Pakistan
3Center of Agricultural Biochemistry and Biotechnology, Pakistan
4National Institute for Biotechnology and Genetic Engineering, Pakistan
5Nuclear Institute of Agriculture, Pakistan
*Corresponding author:Sahar S, Institute of Biotechnology and Genetic Engineering, Pakistan
Submission: April 23, 2019; Published: August 30, 2019
ISSN 2578-0190 Volume3 issues1
Numerous cultures of microorganisms comprising fungi, gram negative and gram-positive bacteria were grown against spice extracts to investigate the antimicrobial properties of these extracts. The results disclosed that ceftriaxone antibiotic was found effective for Enterobacter aerogenes bacterial strains and gentamicin have inhibitory effects against soil bacteria Staphylococcus aureus, while fungal strains remained resistant against the antibiotics. Use of spice extracts showed that using chili and cumin results in the inhibition of Enterobacter aerogenes growth while soil borne bacteria can be controlled by cumin extract. Staphylococcus aureus remained impervious against any extract. The fungi Aspergillus Niger was positively controlled by the extract of cinnamon. Maximum antioxidant activity was recorded 0.57% in cinnamon, whereas phenolic contents regarding cumin red chili and cinnamon in methanol extract was recorded as 0.098%, 0.094% and 0.096% respectively. In case of flavonoid, data disclosed that in water extracts cumin had flavonoid contents about 0.63%, while in methanol extracts cinnamon and red chili had more flavonoid contents recording as 0.959% and 1.98% respectively. The biochemical analyses revealed that the higher phenolic and flavonoid contents along with antioxidant activity in cumin, red chilies and cinnamon may be the main reason behind sturdy inhibitory effect against microbes.
Purpose: Numerous cultures of microorganisms, gram positive and gram-negative bacteria and fungi were grown, using the spice extracts to investigate the antimicrobial properties of these extracts.
Methods: Extracts from different spices were tested for the antimicrobial activity. Bacterial and fungal cultures were grown on the agar medium with small holes filled with different spice extracts.
Results: The results disclosed that ceftriaxone antibiotic was found effective for E aerogenes, and gentamicin has inhibitory effect against soil-borne bacteria, and S. aureus, while fungal strains remained resistant against the antibiotics. Use of spice extracts showed that using chili and cumin extracts results in the inhibition of E aerogenes growth while soil-borne bacteria can be potentially controlled by cumin extract. S aureus remained impervious against any extract. The fungi A Niger was positively controlled by the extract of cinnamon. Maximum antioxidant activity was recorded to be 0.57% in cinnamon, whereas phenolic contents regarding cumin, red chili and cinnamon in methanol extract was recorded as 0.098%, 0.094% and 0.096% respectively. In case of flavonoid, data disclosed that in water extracts cumin had flavonoid contents about 0.63%, while in methanol extracts cinnamon and red chili had more flavonoid contents recording as 0.959% and 1.98% respectively. The biochemical analyses revealed that the higher phenolic and flavonoid contents through antioxidant activity in cumin, red chilies and cinnamon may be the main reason behind steady inhibitory effect against microbes.
Conclusion: Spices in foods have phenolic and flavonoid contents in different quantities that have well observed antimicrobial and antioxidant properties. The increased use of antibiotics can be overcome by developing new kinds of medicines from these spices. This alternative source against microbes will help to manage the antibiotic resistance in microbes against some common antibiotics as well as in reduction of antibiotic usage.
Keywords: Medicinal herbs; Microorganisms; Extracts; Antimicrobial activities
Ancient history showed that use of plants extracts is not new. It has been used to inhibit microbial growth that can cause various diseases. The plant extracts comprise several chemicals which can be tested against detrimental activities of microbes. Currently, the global interest is mounting to study the bioactive compounds from flowers, leaves, peels and seeds to suppress microbial activities which ultimately promote the health [1]. Several different and new drugs are available in the market developed from different plant sources for the treatment of contagious ailments induced by fungi, bacteria, and viruses, which are the foremost problems regarding human health to the current scenario of the changing climate [2]. Worldwide increased consumption of different antibiotics has developed resistance in pathogens against many antibiotics. This antibiotic resistance is detrimental to human race, because injudicious and excessive use of antibiotics can control disease at the time but developed resistance in microbes will be perpetual against that antibiotic (Figure 1). Development of multi-drug resistance in microbes is a serious threat to millions of lives causing decreased efficacy and resistance against commonly available antibiotics [3]. The world scientific community has apprehended the significance of the newly developed medicines to overcome the incipient issues of resistance to available drugs (Figure 2). The antimicrobial effects of methanol, hexane and ethyl acetate extracts was tested from different parts of seeds as well as fruits of Illicium graffiti against gram negative and gram-positive bacteria as well as fungi [4]. The affectivity of extracts revealed that the growth of S. aureus was overcome by ethyl extracts of fruits, showing the significant action against the bacterial strains. There was not any notable effect of fruit ethyl extract against fungi (Figure 3). Another study was conducted by Pritam et al. [5], in which two essential oils from cinnamon species (i.e., Cinnamomum zeylanicum and Cinnamomum cassia) were compared based on their antimicrobial activity to develop the essential oil sprays to stop the putrefaction of foods (Figure 4). The food spoilage bacteria, i.e., E. coli and S. aureus were tested against antibacterial activity of essential oils. Both essential oils were tested along with gentamycin as a positive control. Results showed that S aureus was subtle against the both essential oils (Figure 5). The results also revealed that the essential oils from Cinnamomum cassia were highly proficient against the E. coli; Nimje et al. [5]. The use of spices in the kitchen and in the households is common to avoid the putrefaction of food stuff. However, drug development from spice extracts is a snubbed area. The spice extracts are with exciting antimicrobial properties [6], hence the purpose of this study was to inquire the effect of these extracts in methanol and water against the microorganisms to describe the various spices having biochemical properties which may have impressive antimicrobial activity.
Figure 1:

Figure 2:

Figure 3:

Figure 4:

Figure 5:Antimicrobial activity of spice extracts against E. aerogenes, compared with standard antibiotics (Amikacin, Metronidazole, Ceftriaxone).

Extracts from the spices, staranise (Illicium verum), cinnamon (Cinnamomum verum), the dundicut chili peppers (cultivar of either Capsicum annum or Capsicum frutescens), red pepper (Capsicum annum), black cardamom (Amomum costatum or Amomum costatum), and cumin (Cuminum cyminum) were tested for the antimicrobial activity. The biochemical analysis was allowed to govern the role of these flavors in the inhibition of fungal and bacterial growth. Bacterial and fungal cultures were grown on the agar medium which was prepared according to following recipe; Glucose 6g, peptone 2g, NaCl2g and agar 4g, all these ingredients were dissolved in 100ml distilled water followed by sterilization by using autoclave (121 ᵒC, 15psi and 20min). The sterilized media was cooled down and transferred in sterilized petri-plates in the laminar air flow to avoid contamination. Small holes were made in petri-plate after solidification of medium using sanitized pipette tips. Extracts of spices was filled in holes and tabbed accordingly. Then these plates were cultured with serial diluted suspension of bacterial/fungal cultures by using sterilized swab to spread the cultures on the whole plate. The cultured petri-plates were wrapped with cling film and incubated at 37 ᵒC providing 24 and 72 hours for bacterial and fungal cultures respectively. Inhibition zones were formed around the hole where spice extract was present. Antimicrobial activity was determined by comparing the research results with a positive control. The inhibition zone was compared with the positive control in which antibiotics (Amikacin, Ampicillin, Erythromycin, Ceftriaxone, Clindamycin, Gentamicin, Metronidazole, Penicillin G and Tetracycline) were used to control bacterial/fungal growth (Figure 6).
Figure 6:Antibacterial activity of spice extracts against Soil bacteria, compared with standard antibiotics (Gentamicin, Penicillin-G, and Clindamycin).

To prepare aqueous and methanol extracts, dehydrated 50g spice sample was crushed and grinded with glass powder in the presence of distilled water and 90% methanol. The centrifugation of commixture at 7000rmp was done for 15 minutes. In 100ml volume, in a flask, the supernatant was separated, and filtration was done through Whatman filter paper no. 1 and repeated over again. The 25ml ultimate volume of filter along distilled water or 90% methanol was prepared. During this research few composites of total protein, total sugar, antioxidants, and phenolic content, reducing sugar and flavonoid contents were resolved (Figure 7).
Figure 7:Antibacterial activity of spice extracts against S. aureus, compared with standard antibiotics (Gentamycin, Erythromycin, and Tetracycline).

Chatterjee et al. [7], did the extraction of methanol from black cardamom, cinnamon, staranise, red chili, and black cumin by using phenol sulfuric acid method and from 10% water the total sugar content was determined. To calculate the total sugar amount from samples, a standard curve was generated. In 0.05ml of 80% phenol solution and 2.5ml concentrated sulfuric acid, the 0.5ml of test solution was mixed and kept at room temperature (20-25 ᵒC) after gentle mixing. On spectrophotometer at 485nm the absorbance was detected. By using the altered concentrations of glucose, the standard curve was generated.
Miller et al. [8] developed a method for determination of reducing sugars using dinitro salicylic acid (DNS), the same method was used in this study. From all the spices, 10% of methanol extract and water were used. The calculated results were collected by using the glucose standard curve. In a test tube, the 2.0ml of DNS and 2.0ml of test solutions were added. The mixture was accurately assorted and allowed to heat for 5 minutes in a boiling water bath. The tubes could cool after 5 minutes in a tap water. The spectrophotometer was used to measure the color intensity which was detected at 540nm beside the reagent blank. The standard curve equipped with altered concentrations of glucose was used to calculate the amount of reducing sugars.
By Lowry method the extraction of methanol of all flavors and total protein contented of 10% was resolved. The calculation of concentration of test solution was carried out through standard curve and 0.5ml test solution was added to 2.5ml solution of alkaline copper substance. The mixture in a reaction was permitted to stand at room temperature for 10 minutes and was diversified smoothly. The reagent of Folin Ciocalteu in diluted form in 0.25ml concentration (1:1 v/v, aqueous) was added and kept in an incubator at room temperature for time period of 30 minutes. After 30 minutes, by using the spectrophotometer at 750nm the absorbance was detected. The different concentrations of bovine albumin were used to make a standard protein curve.
The method of Voces et al. [9] with slight changes was used to determine the antioxidant activity of 10% water and methanol extractions from all spices. For calculation of results, the α-Tocopherol standard curve was used. The combination of 2ml of chemical (0.6M sulphuric acid, 28mM sodium phosphate and 4mM ammonium molybdate) with test sample of 0.2ml. The tubes were properly covered and kept in an incubator in hot water bath at 95 ᵒC for 90 minutes and allowed for cooling at room temperature and the spectrophotometer was used for measuring the absorbance which was 695nm showed against the blank. The α-Tocopherol having altered concentrations was used to make a standard curve (Figure 8).
Figure 8:Antifungal activity of spice extracts against A. flavous, compared with standard antibiotics (Gentamicin, Tetracycline and Penicillin-G).
The phenolic content included 10% water and the extracted methanol included black cumin, black cardamom, staranise, cinnamon and red chili was analyzed by a method using spectrophotometer, Folin-Ciocalteu method described by Yasoubi et al. [10]. Using the garlic acid standard curve, the results were collected. In the test sample, 1ml Folin-Ciocalteu and 9ml water were mixed making a dilute solution, in which 0.8ml sodium carbonate was added, then gently mixed for 30 minutes and left at room temperature. For the blank, the test solution was prepared by the substitution of the dilution solution. The absorbance was checked for the blank at 765nm by a spectrophotometer. A standard curve constituting different concentrations of the garlic acid was made.
The method of determining flavonoid content using aluminum chloride calorimetric method of 10% water and extracted methanol from black cumin, black cardamom, star anise, cinnamon and red chili was developed by Kim et al. [11]. Using the quercetin standard curve, the results were obtained. The test sample of 0.1ml was added to the 0.3ml of 5% sodium nitrate into which 0.3ml of aluminum chloride was added after 5 minutes and after another 5 minutes, 2ml of 1M sodium hydroxide was added. The final volume was made 10ml with distilled water. For the blank, the test solution was prepared by the substitution of the dilution solution. The absorbance for the blank at 510nm was checked with a spectrophotometer. A standard curve constituting different concentrations of the quercetin was made.
Table 1 shows the results of antibiotics against different bacteria, according to these results, antimicrobial activity against E. aerogens by ceftriaxone was better as compared to amikacin and metronidazole. In case of soil bacteria, clindamycin was not efficient while gentamycin showed effective results followed by penicillin G. Gentamycin was most effective against S. aureus followed by tetracycline, and erythromycin. Geetha et al. [1], conducted a research on vegetable peel extracts against water-borne pathogens as well as other bacteria. In this research, ampicillin was marked as efficient against all the tested microorganisms. According to their results, the vegetable peel extracts were considered as microorganism specific. Table 2 is presenting the antibacterial activity of diverse extracts from various spices. Cumin and red chili extracts were found very effective against bacterial species i.e., E. aerogens. In case of soil bacteria, cumin extract was more effective then red chili extract. However, cinnamon, staranise and black cardamom extracts also remained futile against soil bacteria. While, S. aureus remained resistant against all the mentioned spice extracts. Chanda et al. [12], observed the activity of antimicrobials from numerous extracts of peels of different fruits. Mango (Mangnifera indica) peel extract showed high level of effectiveness and retain robust antibacterial activity. Eeuteya et al. [13] revealed that clove retain superlative antibacterial activity after ginger and pepper. Gram negative bacteria were somehow resistant while gram positive bacteria were susceptible to spice extracts (Figure 9).
Figure 9:Antifungal activity of spice extracts against A. niger compared with standard antibiotics (Penicillin-G, Tetracycline, and Ampicillin).

Table 1:Standard inhibition zone of antibiotics against bacterial species.

Size of inhibition zone: +ve= Small, ++ve= Medium, +++ve Large zone and –ve= No zone.
Table 2:Antibacterial activity of different spice extracts.

Size of inhibition zone: +ve= Small, ++ve= Medium, +++ve Large zone and –ve= No zone.
Antibiotics like ampicillin, penicillin G. and tetracycline were tested against A. flavous and A. niger strains, not any antibiotic was affective against these fungi as showing in the Table 3. While Table 4 shows the results of different spice extracts against fungi. Data presented that only cinnamon was found effective against A. niger and not any other spice extract was effective for this strain. While A. flavous remained resistant against all the spice extracts.
Table 3:Standard inhibition zone of antibiotics against fungal species.

Size of inhibition zone: +ve= Small, ++ve= Medium, +++ve Large zone and –ve= No zone.
Table 4:Antifungal activity of different spice extracts.

Size of inhibition zone: +ve= Small, ++ve= Medium, +++ve Large zone and –ve= No zone.
Spices have several naturally occurring chemicals and mixtures including glycoside, terpenes, phenols, and other compounds with inhibitory affects [14]. Analysis of various spices and their biochemical effect are the clues to determine their antimicrobial activity. Table 5 and Table 6 are showing the results of biochemical analysis of various spices. For water extract, cumin spice was found with highest total sugar content of 22.11mg/ml followed by black cardamom with total sugar 13.29mg/ml and cinnamon with 12.19mg/ml total sugar. In case of methanol extracts, cinnamon was again with highest total sugar content of 20mg/ml then comes star anise with 11mg/ml and chili with 10.5mg/ml. In water extracts, cinnamon was recorded with maximum reducing sugar content of about 10.mg/ml while 11.5mg/ml in methanol extract.
Table 5:Total sugar, reducing sugar and total protein of spices in water and methanol extract.

Table 6:Antioxidant, Phenolic and flavonoid contents of different spices in water and methanol extract.

In the methanol extract, the cinnamon indicated more protein about 10.8mg/ml, because protein solubility is more in methanol than in water (Table-5). Antioxidant activity of cinnamon in water and methanol extract was 0.57mg/ml and 0.56mg/ml respectively. Phenolic content in methanol extract by cumin, cinnamon and red chili was 0.098mg/ml, 0.096mg/ml and 0.09mg/ml respectively. In water extracts and methanol extracts the flavonoid content was 0.63mg/ml while there was more flavonoid content in the red chili, methanol extracts and cinnamon as 1.98mg/ml and 0.959mg/ml respectively (Table-6). Spices have several bioactive compounds like antioxidants, flavonoids and phenols, which are major compounds found in spices. In some spices like cardamom, cinnamon and clove, certain compounds are present with antimicrobial activities such as cinnamon aldehyde, eucalyptol and eugenol [15]. This study suggests that spices have a potential against microbes especially bacteria, thus these can be used for medicine development and as food preservatives [16,17].
Spices in foods have phenolic and flavonoid contents in different quantities as well as antimicrobial and antioxidant properties. These spice extracts in water and methanol, possess antimicrobial efficacy against fungal and microbial species. Spice extracts in water got highest inhibition zone for E. Aerogenes, moderate inhibition zone for soil bacteria while S. aureus remained impervious. In case of fungi, A. niger exhibited inhibition zone against the extract of cinnamon, and certainly no activity in A. flavous. Biomolecules from these spice extracts in 10% water and methanol, varied in amount. Maximum reducing sugar (11.5mg/ml) was present in water extract of cinnamon while maximum total sugar (22.11mg/ ml) was present in water extract of cumin. Maximum total protein (10.8mg/ml) was obtained from methanol extract of cinnamon. The increased use of antibiotics can be overcome by developing new medicines from these spices. This alternative source against microbes will help to manage the antibiotic resistance in microbes as well as reduction in antibiotic usage.
We would like to thank the Sir Khalil Ahmed (Supervisor) senior Scientist at Nuclear Institute of Agriculture (NIA, Tandojam) for his gratitude towards this work.
© 2019 Sahar S. This is an open access article distributed under the terms of the Creative Commons Attribution License , which permits unrestricted use, distribution, and build upon your work non-commercially.
a Creative Commons Attribution 4.0 International License. Based on a work at www.crimsonpublishers.com.
Best viewed in